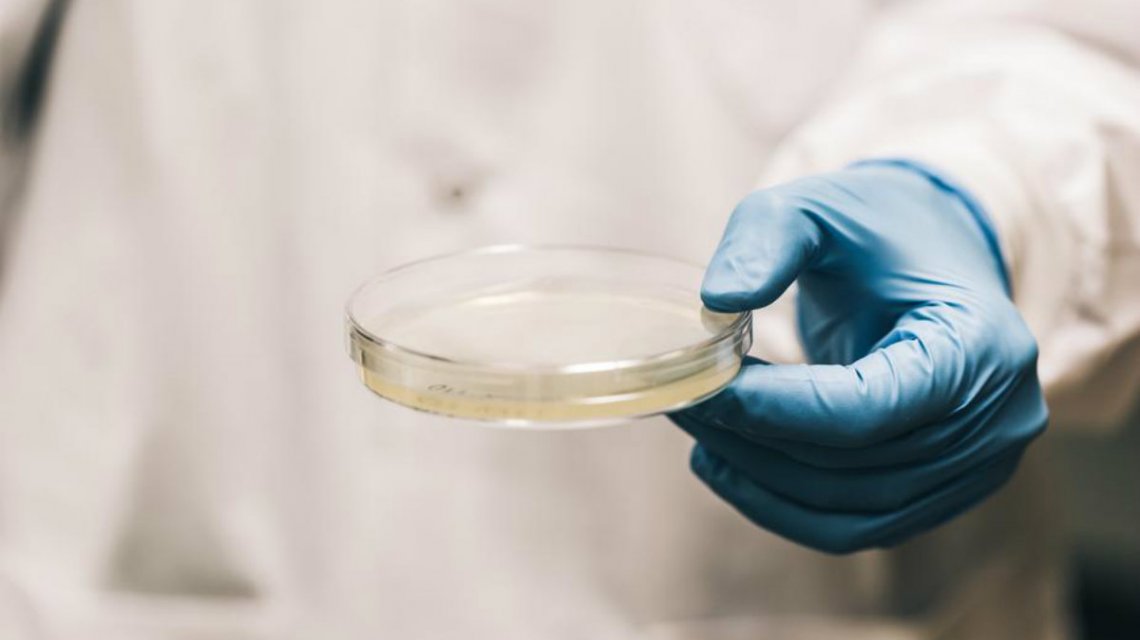

Internan a una nena en el Hospital Penna con Síndrome Urémico Hemolítico
Una niña con Síndrome Urémico Hemolítico es atendida en el Hospital Penna, confirmó la Asociación de Prevención del SUH, que dirige Miguel Ángel Caracciolo.
La menor de dos años, que se encuentra estable, ingresó al nosocomio el pasado 8 de noviembre, proveniente de Coronel Suárez.
Los médicos que la atendieron confirmaron que la pequeña había contraído la enfermedad, aunque no determinaron las causas.
Comentarios
